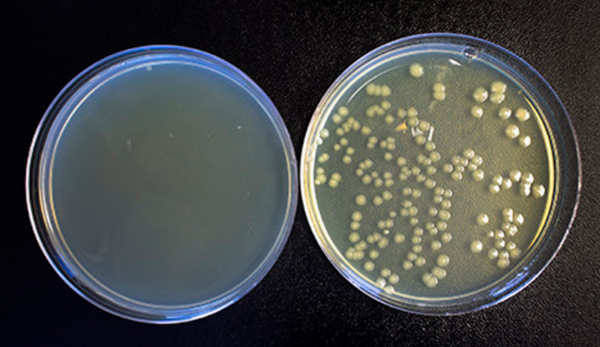
技术资料图片3

技术资料/正文
1442 人阅读发布时间:2020-07-30 16:09
在精准医学的背景之下,“液体活检”可谓是集万千宠爱于一身的热点之一。液体活检(Liquid biopsy),就是用你的体液比如血液、淋巴液、尿液、唾液、母乳、眼泪、汗液等来检测你患病与否。目前,大部分针对液体活检的研究集中在血液和尿液上。
尿液是肾脏排出的代谢废物,可以反映出人体健康方面的诸多信息,比如红细胞异常、白细胞异常、尿蛋白异常等。获得了尿液后,可对其进行生物标志物的筛查。液体活检尤其可针对肿瘤相关信息进行诊断、监测、预后评估,由于其在肿瘤检测中存在巨大潜在应用价值,因此受到全世界生物医学界的青睐。

如何收集和保存尿液中DNA,RNA和蛋白质呢?艾美捷科技作为专业的生命科学领域解决方案供应商,为您推荐Norgen Biotek品牌的尿液收集与保存管。

| 产品名称及描述 | 货号 | 上样量 | 规格 | 产品说明 |
| Urine Collection and Preservation Tube 5 cc | 18116 | 1-5ml | 1管 | 详情 |
| Urine Collection and Preservation Tube 5 cc (50 Units) | 18118 | 1-5ml | 50管 | 详情 |
| Urine Collection and Preservation Tube 15 cc | 18120 | 5-15ml | 1管 | 详情 |
| Urine Collection and Preservation Tube 15 cc (50 Units) | 18122 | 5-15ml | 50管 | 详情 |
| Urine Collection and Preservation Tube 50 cc | 18111 | 5-45ml | 1管 | 详情 |
| Urine Collection and Preservation Tube 50 cc (50 Units) | 18113 | 5-45ml | 50管 | 详情 |
| Urine Collection and Preservation Cup 120 cc | 18129 | 100-120ml | 1个 | 详情 |
尿液收集与保存管特点和优势:
1.RNA / microRNA / DNA / 蛋白质在室温下可保存2年以上;
2.可适用于大多数DNA,总RNA,microRNA和蛋白质分离方法;
3.抑制微生物的生长,从而实现低表达靶标的更高灵敏度的分离;
4.防腐剂使尿液无菌(非感染性),同时保持DNA,RNA,外泌体和蛋白质的完整性。
Norgen的尿液防腐剂:
| 产品名称及描述 | 货号 | 规格 | 产品说明 |
| Urine Preservative Single Dose | 18124 | 1个 | 详情 |
| Urine Preservative Single Dose (50 Units) | 18126 | 50个 | 详情 |
Norgen的尿液防腐剂特点和优势:
1.专为快速保存新鲜尿液样本中的DNA,RNA,microRNA和蛋白质而设计;
2.可防止革兰氏阴性和革兰氏阳性细菌和真菌的生长,并且还可灭活病毒,从而可以安全地处理和运输所产生的非感染性样本。
3.可以保留脱落的细胞,细菌细胞和病毒而不会溶解它们;
4.客户无需立即处理或冷冻样本,样本可在环境温度下运输以便测试。
将革兰氏阴性细菌掺入使用Norgen尿液防腐剂(9 mL尿液和1 mL尿液防腐剂)收集的尿液中,并在37°C温育多达6天。在第6天没有活细胞残留。
Norgen尿液收集与保存管中DNA和RNA稳定性,厂家测试结果:
将两个50mL尿液样本收集到尿液收集和保存管(50cc)中并与干燥的防腐剂充分混合。在-20℃,4℃,室温和55℃下储存长达6个月。随后在保存时长为0个月,1个月,2个月,4个月和6个月的尿液样本中分离出DNA和RNA。分别以分离的DNA(图A)和RNA(图B)作为RT-PCR反应和逆转录RT-PCR反应中的模板用作以检测5S基因。

可以看出,所有DNA和RNA样本都被成功扩增。此外,在所有4个温度下储存的保存的尿液DNA和RNA的质量从0个月到6个月没有变化,如图Ct值保持一致。储存在55°C的尿液样本可以推断是加速老化的结果,因此在55°C下储存6个月的样本与在室温(24°C)下保存2.5年的浓缩尿液表现出相同的稳定性。因此,在Norgen尿液收集与保存管中的尿液样本中的DNA和RNA在室温下可稳定保存长达2.5年。
Norgen尿液收集与保存管的精彩文章鉴赏:
Norgen Biotek成立于1998年,公司总部位于加拿大,是一家著名全球化生物技术公司,生产基于专利技术的核酸和蛋白质纯化及富集产品用于研究和诊断。Norgen Biotek 在2003年获得加拿大国家研究委员会颁发的科技创新奖,是一家致力于样品制备并获得ISO 9001(产品质量)、ISO 13485(产品可用于商业化的医疗设备,包括用于体外诊断领域)和ISO 15189(可用于临床检测机分子诊断领域的研发能力)认证的生物科技公司。目前该公司的产品多达700余种,提供一流的样品制备试剂盒,应用于基因组和蛋白组等不同的领域。
艾美捷科技与国内外优秀的生物试剂供应商保持着密切的合作关系,目前已成为众多国际知名品牌的中国总代理或一级代理,主要包括:Abbkine、AAT Bioquest、Abnova、Agrisera、Alomone Labs、Biovision、Biosensis、Cayman Chemical、Caisson Labs、Cytoskeleton、Epigentek、Equitech-Bio、Hycult Biotech、Jackson、LifeSensors、ProSpec、PhytoAB、Norgen Biotek、iRegene、StressMarq、Trevigen、ImmunoReagents、SouthernBiotech、Origene、US Biological等,可以在第一时间为用户提供最前沿的专业资讯、完备的产品及物流服务。
作为Norgen Biotek在中国的区域总代理,艾美捷科技有限公司将为中国客户提供最全面的Norgen Biotek产品以及订制服务。
